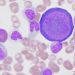
Προσοχή στον Παρβοϊό: Τι να γνωρίζουν γονείς & παιδιά

Αυξημένος σε σχέση με πέρυσι θα είναι ο αριθμός των εισακτέων στα πανεπιστήμια της χώρας για το επόμενο ακαδημαϊκό έτος 2024-2025. Ήδη λαμβάνονται οι τελικές αποφάσεις για τους εισακτέους ανά τμήμα, ώστε ο αριθμός να ανακοινωθεί πριν από την έναρξη των Πανελλαδικών Εξετάσεων την Παρασκευή 31 Μαΐου. Φέτος υπάρχει η προσθήκη ενός νέου τμήματος και κατανομή τμημάτων σε περισσότερα του ενός πεδία.
Στην Ηλεία θα συμμετάσχουν στις Πανελλαδικές εξετάσεις συνολικά 1.105 παιδιά και συγκεκριμένα 769 στα ΓΕΛ και 336 στα ΕΠΑΛ
Ειδικότερα, οι θέσεις των εισακτέων στα ΑΕΙ θα είναι περί τις 69.000, αυξημένες συγκριτικά με πέρυσι όταν ήταν συνολικά 68.574. Η αύξηση των θέσεων οφείλεται κατά κύριο λόγο στο νέο Τμήμα Ψυχολογίας που θα λειτουργήσει στο Δημοκρίτειο Πανεπιστήμιο Θράκης, με έδρα στο Διδυμότειχο.